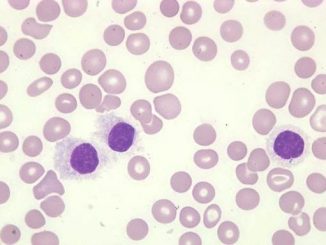

Leukemija: Da li znate koji su simptomi raka krvi? (sve o leukemiji kod odraslih i dece)
Šta su to leukemije? Kakve leukemije postoje? Mogu li se leukemije lečiti i izlečiti? Akutne leukemije, u narodu znane kao rak krvi, a u bukvalnom […]

Šta su to leukemije? Kakve leukemije postoje? Mogu li se leukemije lečiti i izlečiti? Akutne leukemije, u narodu znane kao rak krvi, a u bukvalnom […]

Poremećaj nastaje usled primarne atrofije kore nadbubrežne žlezde, usled čega nadbubrežna žlezda ne luči hormone. U 80% slučajeva nastaje zbog atoimunosti protiv kore nadbubrega. Poremećaji […]

Giht je oblik upalnog artritisa koji se razvija kod nekih ljudi koji imaju visok nivo mokraćne kiseline u krvi. Ova kiselina može formirati igličaste kristale […]

Šta su krajnici (tonzile) i koji krajnici kod ljudi postoje? Krajnici ili stručnije rečeno tonzile, predstavljaju limfatične organe, koji učestvuju u imunoj odbrani organizma, i sastavljeni […]

Heliko bakterija, tj. Helicobacter pylori je gram-negativna bakterija koja najčešće naseljava želudac i dvanaestoplačno crevo čoveka. Najnovija istraživanja u Africi pokazala su da je čovek […]

Stomačni virus je iz prehladu drugo najčešće oboljenje koje napada ljudski organizam. Poznat je i pod nazivom virusni gastroenteritis. Međutim, to nije isto što i […]

Bronhijalna astma podrazumeva hroničnu upalu (inflamaciju) disajnih puteva koja dovodi do suženja disajnih puteva i tegoba u vidu sviranja u grudima (vizinga), otežanog disanja, osećaja […]
Trombocitopenija je medicinsko stanje koje se odnosi na mali broj trombocita u krvi. Trombociti su bezbbojne krvne ćelije koje imaju važnu ulogu u zgrušavanju krvi. […]

Sinuzitis – upala sinusnih šupljina tj. sluznice nastaje posredstvom provocirajućih agenasa, kao što su bakterije, virusi kao i kontinuirano izlaganje alergenima. Samo u slučaju destrukcije […]

Mortonov neurom – kod osobe koja ima ovaj sindrom ima osećaj da ima šljunak u cipeli ili da joj je čarapa nagužvana. To je bolno […]
Copyright © 2026 | WordPress Theme by MH Themes